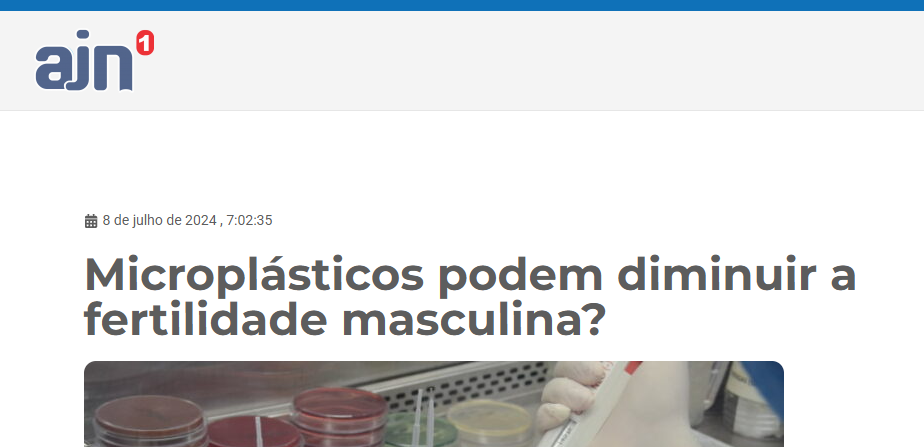

Um estudo publicado no American Journal of Men’s Health revelou a presença de microplásticos em tecidos humanos — incluindo testículos. As partículas, provenientes de objetos comuns como garrafas PET, cosméticos e embalagens alimentícias, têm menos de 5 mm e foram identificadas em quatro das cinco amostras examinadas.
A descoberta reacende o debate sobre os possíveis impactos dessas substâncias na saúde reprodutiva masculina.
Queda histórica na contagem de espermatozoides
O especialista em reprodução humana Dr. João Guilherme Grassi aponta que a contagem média de espermatozoides caiu drasticamente ao longo das últimas décadas:
- 1973: média de 335,7 milhões
- 2018: média de 126,6 milhões
Essa redução pode estar relacionada a fatores como:
- exposição a poluentes (incluindo microplásticos)
- má alimentação
- sedentarismo e obesidade
- contato crônico com toxinas ambientais
O que mostra a pesquisa científica até agora
Estudos em animais já indicam um possível efeito negativo dos microplásticos na fertilidade masculina.
Evidências em roedores
A pesquisa “Reproductive toxicity of polystyrene microplastics” (2021) demonstrou que:
- ratos que consumiram água com microplásticos apresentaram menor número de espermatozoides
- houve indícios de toxicidade testicular e maior estresse oxidativo
Microplásticos em testículos humanos
Outro estudo, publicado na Toxicological Science (2024), encontrou microplásticos:
- em testículos de cachorros, com forte associação à queda na contagem espermática
- em testículos humanos analisados post-mortem — com três vezes mais partículas do que nos cães (mas sem possibilidade de correlacionar diretamente a danos reprodutivos)
Ainda não há provas conclusivas ligando microplásticos à infertilidade humana, mas os dados acendem um alerta importante.
O que dizem os especialistas
“Precisamos de mais estudos que comprovem a relação dos microplásticos com a queda na fertilidade masculina, mas as descobertas atuais são um passo importante nessa direção.”
— Dr. João Guilherme Grassi
Pesquisadores defendem que a presença dessas partículas no sistema reprodutivo humano é suficiente para justificar investigações mais profundas.
O que são microplásticos?
Microplásticos são fragmentos de plástico com menos de 5 mm, originados de:
- desgaste de embalagens
- cosméticos esfoliantes
- roupas sintéticas
- produtos de limpeza
- plásticos quebrados no ambiente
Essas partículas já foram encontradas em:
- água potável
- frutos do mar
- sal de cozinha
- ar atmosférico
- tecidos humanos
Seus efeitos no organismo ainda são pouco compreendidos, mas estudos indicam potencial inflamatório, disruptor endócrino e tóxico a longo prazo.
Fonte:
https://ajn1.com.br/urbano/microplasticos-podem-diminuir-a-fertilidade-masculina/
https://londrix.com.br/microplasticos-podem-diminuir-a-fertilidade-masculina/
https://diariodenoticiasmarilia.com.br/microplasticos-podem-diminuir-a-fertilidade-masculina/
https://www.portalsaudenoar.com.br/microplasticos-podem-diminuir-a-fertilidade-masculina/



